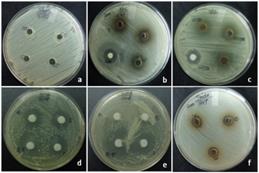
89

Int J Pharm Pharm Sci, Vol 8, Issue 2, 47-50Original Article
IN VITRO CYTOTOXICITY AND ANTIMICROBIAL EFFICACY OF THEVETIA PERUVIANA SEED KERNEL EXTRACTS
NESY E. A.1, LIZZY MATHEW2
1Department of Botany, K K T M Govt. College, Pullut, Trichur, Kerala, India, 2Department of Botany, St. Teresa’s College, Ernakulam, Kerala, India
Email: nesyiby@yahoo.in
Received: 19 Mar 2015 Revised and Accepted: 12 Dec 2015
ABSTRACT
Objective:Whole plant and various parts ofThevetia peruviana were reported to possess several pharmacological properties, due to the vast array of secondary metabolites. The present investigation was carried out to illustrate the cytotoxic and antimicrobial properties of seed kernel extracts on two tumor cell lines and various human skin-pathogenic microbes.
Methods:Cold methanol extracts and successive soxhlet fractions of seed samples were incubated with tumor cell lines in vitro for 3 h at 37 oC, and cell viability was assessed by trypan blue exclusion method. Antimicrobial efficacy was detected by well diffusion protocol against five bacterial strains and two fungal strains at varying concentrations ranging from 10-0.025 mg/6 mm wells, using different fractions from three color variants.
Results:Of the evaluated samples, cold extract of seed kernels has potent cytotoxicity, with IC50 values 0.458 and 0.522 mg/ml on both cell lines than soxhleted ethyl acetate (EA) fractions (0.851 and 0.712 mg/ml). Antimicrobial efficacy against Pseudomonas aeruginosa (18.67±1.15 mm), Nocardia asteroids (15.00±0.00) and Candida albicans (14.33±0.58) strains were effective for EA (10 mg/well) than chloroform (CH) and methanol (MT) fractions, but lower concentrations of CH fractions showed higher sensitivity against C. albicans.
Conclusion:Cytotoxic properties of seed kernels could be utilized against various human cancer cell lines to reduce tumor growth, and the bactericidal and fungicidal efficacy would be helpful in eradicating some common human skin infectious pathogenic microbes.
Keywords:In vitro cytotoxicity, Tumor cell lines, Skin pathogens, IC50 values.
© 2016 The Authors. Published by Innovare Academic Sciences Pvt Ltd. This is an open access article under the CC BY license (http://creativecommons.org/licenses/by/4.0/)
INTRODUCTION
Use of natural products as anticancer agents began with folk medicine, and has been incorporated into ayurvedic and allopathic systems over the years [1]. Herbal anti-cancer compounds are unique in their feature of having anti-oxidant and immune-stimulant activity, preventing cancer growth indirectly along with a direct cytotoxic effect towards malignant and other apoptotic cells [2]. A wide variety of natural compounds in traditional medicinal plants appeared to possess significant cytotoxic as well as chemo preventive activities. Extracts of Curcuma longa, Desmodium triangulare, Drosera indica, Ocimum sanctum, Orthosiphon thymiflorus, Tinospora cordifolia, Zingiber officinale, etc. possessed significant antitumor potential against tumor cell lines Dalton’s Lymphoma Ascites, Ehrlish Ascites Carcinoma and Human Skin Carcinoma cell lines [3-6].
Genus Thevetia and allied genera of Apocynaceae family are considered as a storehouse of many secondary metabolites, especially cardiac glycosides. Even though, they are mainly used in the treatment of congestive heart failure and cardiac arrhythmia, their reported efficacy of inducing apoptosis in tumor cells is noteworthy [7-8]. Studies have revealed the potent cytotoxic and antiproliferative effects of cardiac glycosides in several cancer cell lines, including breast, prostate, lung, renal cancers, melanoma, leukemia and neuroblastoma [9]. Cytotoxic properties of Thevetia seed extracts against human cell carcinoma and brine shrimp larvae were also evaluated [10-11].
Besides being a very popular toxicological ornament having different color blooms in yellow, orange and white shades, the plant is reported to have many curative effects against snake bites, scorpion stings, ringworm, leukoderma, wounds and other skin diseases [12-13]. People living in the warmer climates of India are more prone to skin irritations like itching, burning, blisters, sores, rashes, redness and peeling, when infected with some superficial microbial flora. For many decades, medicinal plants were practiced by folk people for the treatment of skin infections caused by several alarming microbial strains. Hence, the present study was aimed to find significant uses of seed kernels against two tumor cell lines and some selected pathogenic microbes that cause dermatological infections in human beings.
MATERIALS AND METHODS
Cytotoxicity on two tumor cell lines was assessed using 70% methanol extracts of various plant parts. After preliminary screening, successive fractions of kernel extracts from three morpho variants were evaluated to compare the antimicrobial efficacy, in addition to its cytotoxic properties.
Collection of samples
Plants with yellow, orange and white flowers are grown as ornamentals in different localities of Trichur Dist, Kerala. Various plant parts (leaves, flowers, fruit rinds and seed kernels) were collected, washed thoroughly in running tap water, dried in shade for 2-3 w at room temperature, powdered finely in a homogenizer and kept in airtight containers till further assays were done.
Cold extraction
Cold extraction was carried out by shaking 5 g of air-dried, powdered samples with 50 ml of 70% methanol in a magnetic stirrer for 24 h. The supernatant was collected, evaporated to dryness, and were used for cytotoxicity assays, prepared at concentrations ranging from 1.0-4.0 mg/ml.
Hot extraction
Accurately weighed seed kernels (30 g) from three morpho variants were extracted successively [14]using chloroform (CH), ethyl acetate (EA) and methanol (MT) for 12-18 h, after defatting with 300 ml of petroleum ether (PE, 60-80 oC) in a soxhlet extractor. The concentrated extracts were used to prepare working samples at different doses for cytotoxic (0.1-1.2 mg/ml) as well as antimicrobial (10-0.025 mg/well) analysis.
Short-term in vitro cytotoxicity assay
The assay was performed using the trypan blue exclusion method of Talwar [15]. Swiss inbred albino mice are maintained in the Animal house of Amala Cancer Research Centre, Trichur by weekly inoculation with two tumor cell lines: Dalton’s Lymphoma Ascites (DLA) and Ehrlich’s Ascites Carcinoma (EAC). Cell lines were aspirated from the intraperitoneal cavity using a sterile disposable syringe and were suspended in 0.2 M PBS (phosphate buffered saline, pH 7.4). After adjusting the cell density at 1×106cells/ml, it was suspended with varying concentrations of extracts, and incubated for 3 h at 37 oC. Cell viability was assessed by adding 100 µl of trypan blue dye. Using hemocytometer, viable and nonviable cells were counted, and IC50 values were recorded. Control experiments were also carried out in triplicates.
Antimicrobial assay
Pure cultures of all experimental bacteria and fungi were obtained from the Microbial Type Culture Collection and Gene Bank (MTCC), Chandigarh and from Amala Medical Institute of Sciences, Trichur. Pathogenic strains used for the study were three-gram positive bacteria (Staphylococcus aureus, Streptococcus pyogenes, Nocardia asteroids), two-gram negatives (Pseudomonas aeruginosa, Proteus mirabilis) and two fungal strains (Candida albicans and Trichophyton rubrum). Using the standard agar well diffusion protocol [16], in vitro assays of all four fractions were carried out on nutrient agar medium (Hi-media) prepared in UV sterilized disposable petri dishes (Tarson). The labeled plates were inoculated with respective organisms, loaded with samples of varying concentrations; and after the incubation (37 °C) period the zone of inhibition was recorded in millimeters. Gentamicin and Fluconazole (25 & 50 µg/well/disc) were used as positive controls for bacteria and fungi, and dimethyl sulfoxide (DMSO) as a negative control.
RESULTS
Cytotoxicity evaluation using 70% MT crude extract showed that the efficacy differed greatly in various plant parts. The seed kernel extract showed 100% cell death on both cell lines DLA and EAC at a concentration of 1.2 mg/ml. Lower concentrations (0.1-0.2 mg/ml) did not affect the viability of the cells markedly, but as the concentration increased from 0.4 to 0.6 mg/ml, a sudden and drastic increase in cell death was observed. Above this concentration, more than 80 % of the cells were nonviable with a steady increase, and the IC50 values were calculated as 0.458 mg/ml (Fig.1A) and 0.522 mg/ml (fig. 1B) respectively for both DLA and EAC. Meanwhile, the 50 % inhibition values of leaf extracts were observed as 2.5 mg/ml and 2.8 mg/ml, and flower extracts as 3.4 and 3.5 mg/ml, but rind extracts failed to cause death in minimum 50 % of cancer cell lines even at a concentration of 4 mg/ml. After noticing the response of various plant parts, samples were selected that showed the highest efficacy on both tumor cell lines. Accordingly, excluding PE fraction, remaining seed fractions (CH, EA and MT) were evaluated at concentrations ranging from 0.1-1.2 mg/ml. EA fractions of yellow, orange and white flowered plants (YSEA, OSEA, WSEA) showed 50 % cell death at a concentration of 0.851, 1.142 and 1.127 mg/ml on DLA cell lines, whereas EAC cell lines showed better cytotoxic effects with IC50 values 0.712 (YSEA), 0.908 (OSEA) and 0.905 (WSEA) mg/ml. The viability of tumor cells did not lose markedly at the studied concentrations for both CH and MT fractions of three colour variants.


Fig. 1: Cytotoxicity of 70% MT extract of seed kernels on cell lines A) DLA B) EAC
Values are mean±SD
The antimicrobial activity was evaluated at different concentrations (10-1.25 mg/well), and the results were compared among the fractions of three colour variants. The PE fraction or the seed oil could not inhibit the growth of any pathogenic organisms, even though varying concentrations were tested in laboratory conditions. The CH fraction was less effective at higher doses against most of the pathogens but responded effectively at very low concentrations (0.5-0.025 mg/well) against the fungal strain C. albicans (fig. 2 d-e).Among the gram-positive strains, sensitivity (YSEA) decreased in the order N. asteroids (15.00±0.00), S. pyogenes (12.50±0.50) and S. aureus (12.33±0.58). Comparing the activity between white and orange variants, EA fraction of WSEA and OSEA inhibited the growth of P. aeruginosa excellently with 23.67±0.58 and 20.00±1.00 mm clear zones. Among the fungal pathogens, C. albicans was more sensitive (14.33±0.58) than T. rubrum (11.67±0.58) at 10 mg/well. Both bacteria and fungi showed moderate susceptibility to MT fractions with intermediate inhibition zones ranging from 9.67±0.58 to 12.50±0.71 mm (YSMT), and almost identical activity was noticed by other variants (OSMT and WSMT) also (table 1).
Table 1: An antimicrobial activity of EA, MT fractions of seed kernel extracts of three morpho variants (10 mg/50 µl/6 mm well; zone of inhibition in mm)
Organisms |
EA |
MT |
|||||
YS |
OS |
WS |
YS |
OS |
WS |
+ve control |
|
Gram-positive bacteria |
Gentamicin |
||||||
S. aureus |
12.33±0.58 |
13.00±0.00 |
12.67±0.58 |
10.00±0.00 |
13.00±1.00 |
10.67±0.58 |
19.78±1.21 |
S. pyogenes |
12.50±0.50 |
13.00±1.00 |
13.67±0.58 |
11.00±1.00 |
11.00±0.00 |
11.00±0.00 |
15.56±0.87 |
N. asteroids |
15.00±0.00 |
15.33±0.58 |
14.33±1.15 |
11.33±0.58 |
11.33±0.58 |
11.33±0.58 |
22.78±0.39 |
Gram-negative bacteria |
|||||||
P. aeruginosa |
18.67±1.15 |
20.00±1.00 |
23.67±0.58 |
9.67±0.58 |
11.67±0.58 |
10.00±2.00 |
28.33±0.72 |
P. mirabilis |
13.00±0.00 |
10.67±0.58 |
11.00±1.00 |
11.00±1.00 |
12.33±0.58 |
11.67±1.53 |
31.22±0.53 |
Fungal strains |
Fluconazole |
||||||
C. albicans |
14.33±0.58 |
13.00±1.00 |
13.67±0.58 |
12.50±0.50 |
13.50±0.71 |
11.00±1.73 |
11.73±0.82 |
T. rubrum |
11.67±0.58 |
12.67±1.53 |
10.00±0.00 |
12.50±0.71 |
12.00±0.00 |
12.50±0.71 |
13.44±0.58 |
Values are mean±SD; YSEA, OSEA, WSEA, YSMT, OSMT, WSMT-Ethyl Acetate and Methanol fractions of Yellow, Orange and White variant seed kernels
Fig. 2: Antimicrobial activity of different fractions (PE, CH, EA & MT) of Thevetia peruviana seed kernel extracts of three morphovariants and its comparison (concentration mg/well)
a) S. aureus (YSPE: 5, 2.5, 1.25 mg) b) N. asteroids (YSMT, OSMT, WSMT: 10 mg) c) N. asteroids (YSEA, OSEA, WSEA: 10 mg) d) C. albicans (OSCH: 0.5, 0.25, 0.05, 0.025 mg) e) C. albicans (WSCH: 0.5, 0.25, 0.05, 0.025 mg) f) T. rubrum (YSMT, OSMT, WSMT: 10 mg)
DISCUSSION
Cytotoxicity assays normally involve short-term exposure of cultured normal or transformed cells to test substances in order to predict potential toxicity. It also provides insight towards the carcinogenic and genotoxic dispositions of herb-derived compounds and extracts [17]. Among various parameters to detect cytotoxicity, the trypan blue test is often used to measure cell membrane integrity, as it forms a functional barrier around the cells which regulate and interchange molecules into and out of cells.
Present results revealed that cold methanol extract of seed kernels has strong cytotoxic properties compared to hot fractions. A dose dependent and sharp reduction in tumor cell viability has been observed in vitro, against DLA and EAC cell lines. It might be due to speculation that the extracts stimulate the growth and activity of immune cells by the production of interleukins, which target tumor cells and cause lysis of the tumor cells by indirect cytotoxic mechanism [3]. The results implied that seed kernels have a potent anticancer effect on malignant cell lines. But the ability of flower and fruit wall extracts in destroying the tumor cells by destructing their cell walls was found to be relatively poor. However, leaf extracts showed some cytotoxic effects on both cell lines at higher concentrations. Out of various soxhlet fractions of seed kernels, EA extract was found to act fairly better than CH and MT fractions.
The cytotoxic efficacy can be correlated with the amount of cardiac glycosides located in various plant parts. The cytotoxic property of many cardenolides has been previously noted by Hartwell [18]. Two known cardiotonic glycosides, neriifolin and 2’-acetyl neriifolin of Thevetia thevetioides exhibited cytotoxic activities in the KB (human nasopharynx epidermoid carcinoma) in vitro system at 2.2x10-2 and 3.3x10-2 µg/ml [10]. Kumar et al. [19] reviewed the anti-cancerous properties of oleandrin, a cardiac glycoside from Nerium oleander Linn against various cultured cell lines. Similarly, three cardenolide glycosides (neriifolin, 3′-O-methylevomonoside and 2′-acetyl-neriifolin) extracted from the wood of Thevetia ahouai exhibited a distinctive pattern of differential cytotoxicity against human disease-oriented tumor cell lines [20].
Bactericidal and fungicidal efficacy of the seed oil was evaluated and showed that it failed to inhibit the growth of any organisms, even though varying concentrations were applied to the culture plates (fig. 2a). Meanwhile, a skin care herbal lotion was prepared by Kareru et al. [21] using Thevetia seed oil against S. aureus and E. coli, after analyzing its antibacterial properties. Only S. pyogenes and N. asteroids responded with minimum inhibition zones (11.00±1.00) against the CH fraction (10 mg/well), whereas C. albicans responded with maximum inhibition zones (24.00±1.00) at lower doses (0.25 mg/well) of all three morphoforms.
Plant based natural constituents can be derived from any part of the plant like bark, leaves, roots, fruits, seeds and fruit rinds [22]. Studies on the antimicrobial properties of leavesof yellow flowered Thevetia [21] and its seed kernels [23] had proved significant activities against a wide range of bacterial and fungal pathogens. Investigations conducted by Hassan et al. [11] revealed the antidiarrheal and cytotoxic activities against albino rats and brine shrimp eggs. The well-recommended use of seed extracts against agri-horticultural pests [24] and cotton pests [25] were also noteworthy, in addition to its potential usage as fungicides and bactericides against some common infectious microbes [26]. The present results showed that EA fractions have the highest activity against most of the tested organisms than MT fractions, similar to the earlier observations shown by leaf, flower and rind extracts [27-29].
Preliminary screening for secondary metabolites revealed that the seeds were enriched with terpenoids, steroids and cardiac glycosides; of which terpenoids are the precursor molecules of steroids and cardiac glycosides. Most of the secondary metabolites either acted individually or synergistically; and of course, seeds possess promising drug components for cancer therapeutics and microbial disinfection, which can be easily, extracted using cheaper organic solvents.
CONCLUSION
The present study revealed that crude 70% methanolic extract of T. peruviana seeds displayed strong cytotoxic potential against both DLA and EAC tumor cell lines than hot extracts. EA is the most effective solvent in extracting many of the active biomolecules than CH and MT. These solvents could be effectively utilized for the successful extraction of various biomolecules useful against cancer cell lines as well as microbial infections for the development of valuable drugs.
ACKNOWLEDGEMENT
The sincere help rendered by Dr. Ramadasa Kuttan, Director, Amala Cancer Research Centre, Trichur, Kerala for providing necessary facilities for the completion of cytotoxicity studies is greatly acknowledged.
CONFLICT OF INTERESTS
Declared none
REFERENCES
- Valko V, Fickova M, Pravdov E, Nagya M, Grancai D, Czigle S. Cytotoxicity of water extracts from leaves and branches of Philadelphus coronarius L. Biomed Pap Med Fac Univ Palacky Olomouc Czech Repub 2006;150:71-3.
- Adhvaryu MR, Reddy N, Parabia MH. Antitumor activity of four ayurvedic herbs in dalton lymphoma ascites bearing mice and their short-term in vitro cytotoxicity on DLA-Cell-Line. Afr J Tradit Complementary Altern Med 2008;5:409-18.
- Asirvatham R, Christina AJM. Anticancer activity of Drosera indica L. on dalton’s lymphoma ascites (DLA) bearing mice. J Intercultural Ethnopharmacol 2013;2:9-14.
- Jayaseelan RS, Vijayan FP, Mathesvaran M, Suresh V, Padikkala J. Cytotoxic and antitumor activity of methanolic extracts Desmodium triangulare (retz) merr. Root Int J Pharm Pharm Sci 2012;4:540-2.
- Hanafy ZE. Ginger extract antimutagens as cancer chemopreventive agent against ehrlich ascites carcinoma. Acad J Cancer Res 2009;2:61-7.
- Sini KR, Haribabu Y, Sajith MS, Sreekumar SK. The in-vitro cytotoxic activity of (Orthosiphon thymiflorus Roth.) sleensen leaf extract against dalton lymphoma ascites cell line. J Chem Pharm Res 2012;4:917-21.
- Li H, Zhou H, Wang D, Qiu J, Zhou Y, Li X, et al. Versatile pathway-centric approach based on high-throughput sequencing to anticancer drug discovery; 2012. Available from: www.pnas. org/cgi/doi/10.1073/pnas.1200305109. [Last accessed on 10 Feb 2015].
- Mijatovic T, Quaquebeke EV, Delest B, Debeir O, Darro F, Kiss R. Cardiotonic steroids on the road to anti-cancer therapy. Biochim Biophys Acta 2007;1776:32-57.
- Prassas I, Diamandis EP. Novel Therapeutic applications of cardiac glycosides. Nat Rev Drug Discovery 2008;7:926-35.
- Mc Laughlin JL, Freedman B, Powell RG, Smith Jr CR. Neriifolin and 2'-acetylneriifolin: insecticidal and cytotoxic agents of Thevetia thevetioides seeds. J Econ Entomol 1980;73:398-402.
- Hassan MM, Saha AK, Khan SA, Islam A, Zaman MMU, Ahmed SSU. Studies on the antidiarrhoeal, antimicrobial and cytotoxic activities of ethanol extracted leaves of yellow oleander (Thevetia peruviana). Open Vet Sci J 2011;1:28-31.
- Kirtikar KR, Basu BD, An CIC. Indian medicinal plants. Vol. II. Dehra Dun: Bishen Singh Mahendra Pal Singh; 1980.
- Udayan PS, Balachandran I. Medicinal plants of arya vaidya sala, Kottakkal, Kerala: Department of Publications, Arya Vaidya Sala; 2009.
- Harborne JB. Phytochemical methods: a guide to modern techniques of plant analysis. 3rd Edn. New Delhi: Springer (India) private Ltd; 1973.
- Talwar GP. Handbook of practical immunology. New Delhi: National Book Trust; 1974. p. 336-9.
- Navarro V, Villarreal ML, Rogas G, Lozoya X. Antimicrobial evaluation of some plants used in Mexican traditional medicine for the treatment of infectious diseases. J Ethnopharmacol 1996;53:143-7.
- Ifeoma O, Oluwakanyinsola S. Chapter 4. Screening of herbal medicines for potential toxicities. In: New Insights into Toxicity and Drug Testing; 2013. Available from: http://dx.doi.org/ 10.5772/54493. [Last accessed on 10 Feb 2015].
- Hartwell JL. Plants used against cancer: a survey. Lloydia 1967;30:379-436.
- Kumar A, De T, Mishra A, Mishra AK. Oleandrin: a cardiac glycoside with potent cytotoxicity. Pharmacogn Rev 2013;7:131-9.
- Decosterd L, Gustafson KR, Cardellina JH, Cragg GM, Boyd MR. The differential cytotoxicity of cardenolides from Thevetia ahouia. Phytother Res 1994;8:74-7.
- Kareru PG, Keriko JM, Kenji GM, Thiongo GT, Gachanja AN, Mukiira HN. Antimicrobial activities of skincare preparations from plant extracts. Afr J Tradit Complementary Altern Med 2010;7:214-8.
- Gordon MC, David JN. Natural product drug discovery in the next millennium. Pharm Biol 2001;39:8-17.
- Hammuel C, Abdullahi MS, Mankilik M, Anyim BP, Adesina OB, Inekwe UV, et al. The phytochemical and antimicrobial activities of oil from the seed of Thevetia peruviana plant. Appl Environ Biol Sci 2011;1:597-601.
- Panigrahi A, Raut SK. Thevetia peruviana (Family: Apocynaceae) in the control of slug and snail pests. Mem Inst Oswaldo Cruz 1994;89:247-50.
- Bai H, Koshy G. Juvenomimetic activity of extracts of Thevetia neriifolia Juss to Dysdercus cingulatus F. (Hemiptera: Pyrrhocoreidea). J Trop Agric 2004;42:45-7.
- Ravikumar Patil HS, Makari HK, Gurumurthy H. In vitro antimicrobial activity of ethanol extract of Thevetia peruviana. EJEAFChe Electron J Environ Agric Food Chem 2007;6:2318-22.
- Nesy EA, Lizzy Mathew. Studies on antimicrobial and antioxidant efficacy of Thevetia neriifolia, Juss leaf extracts against human skin pathogens. Int J Pharm Sci Drug Res 2014;6:164-8.
- Nesy EA, Jolly CI, Lizzy Mathew. Assessment of in vitro antimicrobial and antioxidant potential of Thevetia neriifolia, Juss. flower morphoforms. IOSR J Pharm Biol Sci 2014;9:11-6.
- Nesy EA, Lizzy Mathew. A comparative evaluation of antimicrobial and antioxidant properties of Thevetia neriifolia, juss fruit rind extracts. Int J Curr Pharm Res 2014;6:47-50.